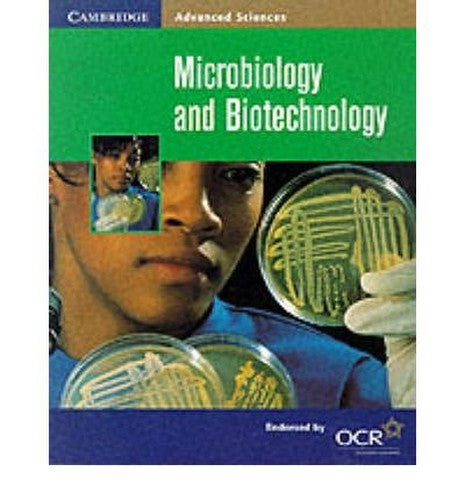
Microbiology and Biotechnology

Microbiology and Biotechnology
Microbiology and Biotechnology
Regular price
Checking stock...
Regular price
Checking stock...
Summary
A range of textbooks for AS and A level Pre 2008 specification.
The feel-good place to buy books
- Free US shipping over $15
- Buying preloved emits 41% less CO2 than new
- Millions of affordable books
- Give your books a new home - sell them back to us!
Microbiology and Biotechnology by Pauline Lowrie
A range of textbooks and teacher support materials for AS and A level Pre 2008 specification. See Cambridge OCR Advanced Sciences for the New 2008 OCR Specification.
Susan Wells is Professor of English at Temple University. Her most recent book is the prizewinning Out of the Dead House: Nineteenth-Century Women Physicians and the Writing of Medicine (2001).
| SKU | Unavailable |
| ISBN 13 | 9780521787239 |
| ISBN 10 | 0521787238 |
| Title | Microbiology and Biotechnology |
| Author | Pauline Lowrie |
| Series | Cambridge Advanced Sciences |
| Condition | Unavailable |
| Binding Type | Paperback |
| Publisher | Cambridge University Press |
| Year published | 2000-10-12 |
| Number of pages | 112 |
| Cover note | Book picture is for illustrative purposes only, actual binding, cover or edition may vary. |
| Note | Unavailable |